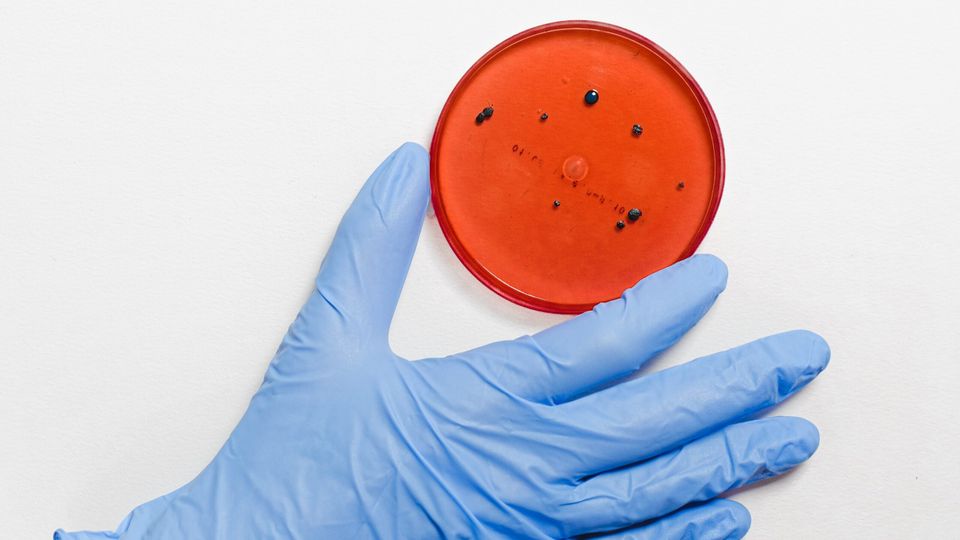

Zuid-Afrikaanse variant coronavirus in onze regio vastgesteld
Afbeelding: Pexels
De ‘Zuid-Afrikaanse mutatie’ van het coronavirus is nu ook in Nederland vastgesteld, en wel in onze regio. Dat meldt het Rijksinstituut voor Volksgezondheid en Milieu (RIVM).
Een persoon uit de regio Midden- en West-Brabant blijkt de variant te hebben opgelopen. De persoon is op 22 december getest en deze donderdag bleek dat het om de nieuwe versie van het virus gaat. Het is niet bekend of de Brabander onlangs in Zuid-Afrika is geweest. Ook is zijn woonplaats niet bekend gemaakt.
Twee extra besmettelijke varianten coronavirus
Er zijn nu twee nieuwe varianten van het coronavirus. Naast de Zuid-Afirkaanse, is er ook de ‘Britse variant’. Die is al bij ongeveer vijftig mensen in Nederland aangetroffen, onder wie ongeveer dertig mensen uit het Zuid-Hollandse Bergschenhoek en omgeving. Een school was daar de brandhaard. Velen van hen waren niet in Groot-Brittannië.
De beide versies lijken besmettelijker te zijn dan andere coronavarianten, maar lijken niet meer gezondheidsschade aan te richten. Volgens de eerste onderzoeken werken de ontwikkelde coronavaccins ook tegen de twee mutaties. Omdat de varianten besmettelijker zijn dan eerdere coronaversies, is de kans groot dat ze over een tijdje meer voorkomen. Als ze besmettelijker zijn en zich dus gemakkelijker verspreiden, kan dit ook betekenen dat het aantal positieve tests en het aantal ziekenhuisopnames voorlopig hoog blijft. Dat virussen muteren, gebeurt heel vaak.
